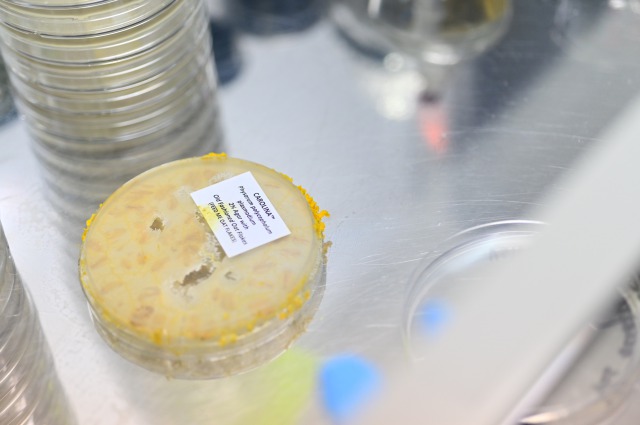
img

21th April

25th April
They have found all their food in four days and will soon make a round.
26th April

27th April
It seems that they have eaten most of the first food I put down.
They have escaped out of the petri dish.

28th April
The escaped slime mold was transplanted into another petri dish. I chose a petri dish of NA agar, filled with black ink.

→Go to “pattern9”